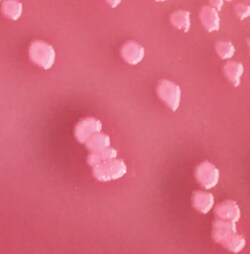

General Microbiology Quality Control Products
Browse through quality control products and organisms used to ensure that results of clinical microbiological testing procedures are accurate. Choose between qualitative and quantitative tests, gram-negative or positive rods and different formats depending on your need.
Useful Links
Save Now - Exclusive Deals
Product Code 12975993
Product Code 12995993
Product Code 12965993
Product Code 13137876
Product Code 12958878
Product Code 12928858
Product Code 12956037
Must Have
Product Code 12926003
Product Code 12966027
Complete Your Order - Great Deals
Product Code 11309283
Product Code 10209252
Product Code 4523110
FAQ
The differences between Gram-negative and Gram-positive rods pertain to their cellular characteristics, staining properties, and implications for QC testing.
- Cell Wall Structure: Gram-Positive Rods: Thick peptidoglycan layer; retain crystal violet stain (purple)
- Gram-Negative Rods: Thin peptidoglycan layer with outer membrane; take up counterstain (pink/red)
- Staining Properties: Gram-Positive Rods appear purple after Gram staining. Gram-Negative Rods appear pink/red after Gram staining
- QC Strain Examples: Gram-Positive Rods: Bacillus subtilis, Clostridium sporogenes. Gram-Negative Rods: Escherichia coli, Pseudomonas aeruginosa
- Growth and Testing: Different growth requirements and media preferences. Varying antibiotic susceptibility, important for antimicrobial testing
- Applications: Gram-Positive Rods: Often spore-forming, relevant for sterility and environmental monitoring. Gram-Negative Rods: Relevant for water testing and contamination control
Acceptable microbial limits for non-sterile pharmaceutical products are defined by regulatory guidelines such as the United States Pharmacopeia (USP) and the European Pharmacopoeia (EP). The limits can vary based on the type of product (e.g., oral, topical). Generally, the limits are:
- Total Aerobic Microbial Count (TAMC):
- Oral products: Not more than 103 CFU/g or CFU/mL
- Topical products: Not more than 102 CFU/g or CFU/mL
- Total Yeast and Mold Count (TYMC):
- Oral products: Not more than 102 CFU/g or CFU/mL
- Topical products: Not more than 101 CFU/g or CFU/mL
- Absence of Specific Pathogens:
- Escherichia coli: Should be absent in 1 g or 1 mL
- Salmonella spp.: Should be absent in 10 g or 10 mL
- Staphylococcus aureus: Should be absent in 1 g or 1 mL
- Pseudomonas aeruginosa: Should be absent in 1 g or 1 mL
When selecting General Microbiology Quality Control (QC) products, consider the following five factors:
- Ensure that the QC products meet regulatory and industry standards, such as those from the United States Pharmacopeia (USP), European Pharmacopoeia (EP), or ISO guidelines.
- Choose QC products that are relevant to the specific microorganisms and tests you are performing, such as sterility testing, bioburden testing, or pathogen detection.
- Select products from reputable suppliers known for high-quality, reliable, and consistent performance. Look for validated and certified products.
- Consider the ease of handling and preparation of the QC products. Ready-to-use formats can save time and reduce the risk of error.
- Check the shelf life and storage conditions of the QC products to ensure they fit your laboratory's capabilities and workflow, and maintain their effectiveness over time.